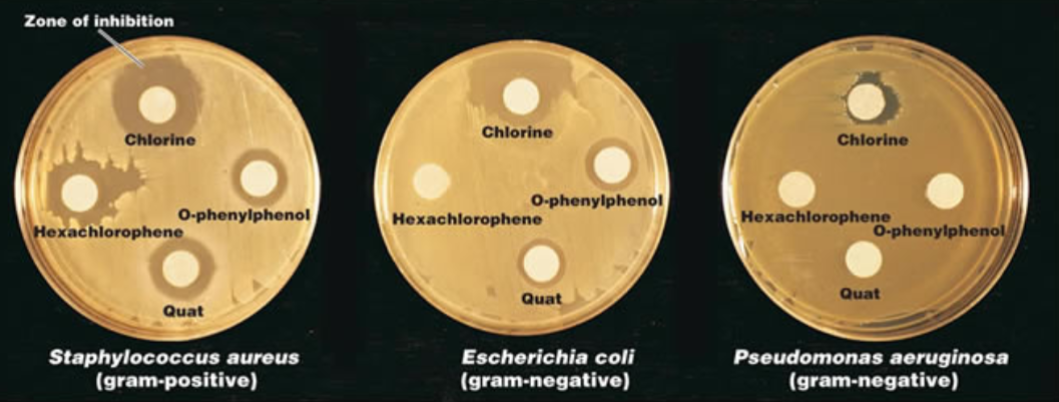
<p>Uses antibiotics containing disks to test whether particular bacteria are susceptible to specific antibiotics</p>
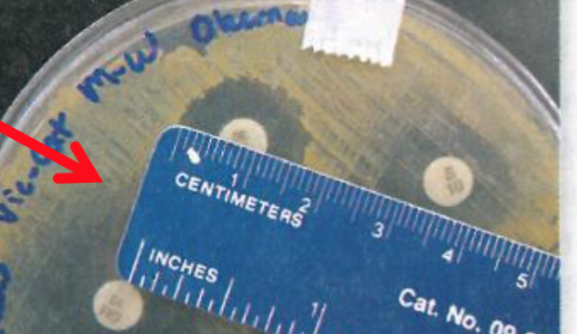
<p>Measurement of circular area around the antibiotic disk</p>

1/19
Looks like no tags are added yet.
Name | Mastery | Learn | Test | Matching | Spaced |
|---|
No study sessions yet.
Chemotherapeutic Drug
Any chemical used in the treatment, relief, or prophylaxis of a disease
Prophylaxis
Use of a drug to prevent potential infection in a person at risk
Antimicrobial Chemotherapy
The use of chemotherapeutic drugs to control infection
Antimicrobials
Any antimicrobial drug, regardless of its origin
Antibiotic
A substance produced by microbes that can inhibit growth or destroy other microbes
Semisynthetic Drugs
Compounds chemically modified in the laboratory after being isolated from natural sources
Synthetic Drugs
Compounds synthesized entirely in the laboratory through chemical reactions
What test can be done instead of the Kirby Bauer test?
Minimum Inhibitory Concentration Test
Kirby-Bauer Method
Uses antibiotics containing disks to test whether particular bacteria are susceptible to specific antibiotics
Kirby-Bauer Antibiotic Sensitivity Test
Media - Mueller-Hinton agar
Media pH - 7.2-7.4
Amount of bacteria - 150 million bacterial cells/ml of liquid
Age of culture for st-up - 2-6 hours old
Times plates are incubated - 18-24 hours
Temperature of incubation - 35-37 °C
Spreading technique - bacterial lawn
Bacterial Lawn
spread 3 different times on agar plate

Zone of Inhabitation (mm)
Measurement of circular area around the antibiotic disk
Results of Kirby-Bauer Test: Resistant
Antibiotic has no effect on the bacteria
Results of Kirby-Bauer Test: Intermediate
Antibiotic is only moderately effective against the bacteria
Results of Kirby-Bauer Test: Sensitive
Antibiotic is effective against the bacteria (prevents growth)
Broad Spectrum Antibiotics
Effective against a large range of bacteria
Narrow Spectrum Antibiotics
Effective against a small group of bacteria
Bactericidal
Kills bacteria
Bacteriostatic
Inhibit reproduction of bacteria, allows immune system to eliminate them
What are the General Actions of Antibiotics?
Cell wall inhibitors
Cell membrane
DNA/RNA
Protein synthesis inhibitors acting on ribosomes
Metabolic pathways & products